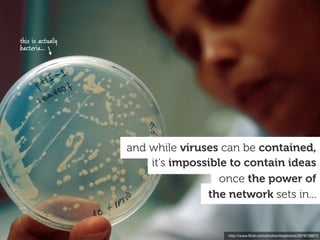
this is actually
bacteria...




                   and while viruses can be contained,
                       it's impossible to contain ideas
                                     once the power of
                                  the network sets in...


                                      http://www.ﬂickr.com/photos/ricephotos/2679758872

The document discusses how technology and the internet have disrupted traditional models of design and consumption. It notes that users now expect to interact with products in nonlinear and unpredictable ways, and can modify or improve upon designs themselves. This shift challenges designers and engineers to create more flexible and open-ended experiences that empower user customization and evolution. It also increases the responsibility of designers to consider the broader implications and impacts of their work.